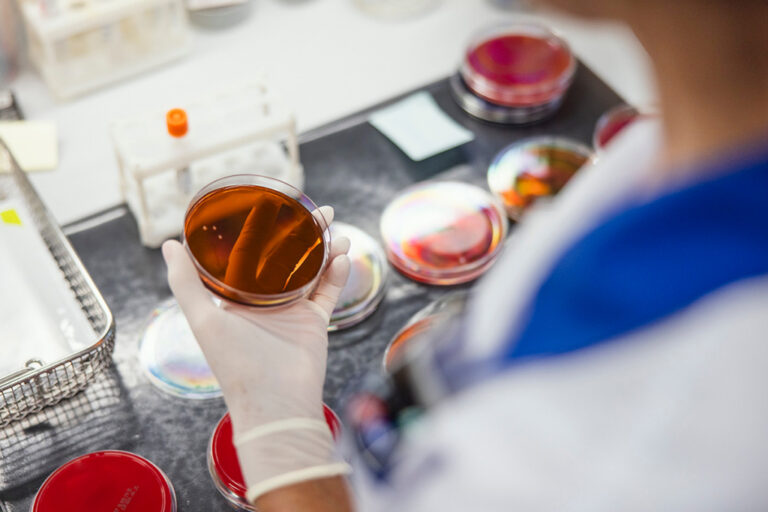

LABRIS teeb igapäevaselt tööd sigade Aafrika katku laborianalüüside usaldusväärsuse tagamiseks
Avaldatud: 9 august, 2025Riigi Laboriuuringute ja Riskihindamise Keskus (LABRIS) on ainus labor Eestis, kus tehakse sigade Aafrika katku (SAK) analüüse. Alates epideemia algusest 2014. aastal oleme teinud enam kui 100 000 SAKi analüüsi, millest positiivseid on olnud üle 3000.
LABRISe direktor Heli Reinet sõnab, et kõik SAKi analüüsid on tehtud akrediteeritud analüüsimeetoditega, mille diagnostiline suutlikkus ja usaldusväärsus on kinnitatud nii siseriiklikult kui Euroopa Liidu referentlaboratooriumi poolt. „Oleme regulaarselt osalenud EL referentlabortooriumi võrdluskatsetes ja saatnud neile täiendavateks uuringuteks üle 400 positiivse proovi. Tulemused on olnud kokkulangevad,” kinnitab Reinet. Proovide EL referentlaborisse saatmise eesmärk on Euroopas ringlevaid viirustüvesid iseloomustada ja haiguse evolutsiooni jälgida.
LABRIS järgib erapooletuse ja konfidentsiaalsuse nõudeid kõikides katsetegevuse etappides alates proovide vastuvõtust kuni analüüsitulemuste väljaandmiseni ning ei ole mõjutatud rahaliselt, äriliselt ega muul survel.
LABRIS on akrediteeritud Eesti Akrediteerimiskeskuse (EAK) poolt ja vastab standardi EVS-EN ISO/IEC 17025:2017 nõuetele kui katselabor loomahaiguste diagnostiliste uuringute ja toidu, sööda, vee, alkoholi, mikrobioloogiliste ja keemiliste analüüside valdkonnas.
Põllumajandus- ja Toiduamet on volitanud LABRISe sigade Aafrika katku ametliku kontrolli laboratooriumiks ning Regionaal- ja Põllumajandusministeerium riiklikuks referentlaboratooriumiks.